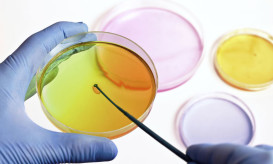

Σοκ! Έως και 98% αντοχή στα αντιβιοτικά εμφανίζουν νοσοκομειακά μικρόβια στην Ελλάδα
Επίσημα στοιχεία από χείλη έγκριτων Ελλήνων λοιμωξιολόγων σοκάρουν! Σχεδόν στο 100% εμφανίζονται ανίσχυρα τα όπλα που έχουν στα χέρια...

Επίσημα στοιχεία από χείλη έγκριτων Ελλήνων λοιμωξιολόγων σοκάρουν! Σχεδόν στο 100% εμφανίζονται ανίσχυρα τα όπλα που έχουν στα χέρια...
Στον εισαγγελέα Πλημμελειοδικών Αθηνών προσφεύγει ο Ιατρικός Σύλλογος της Αθήνας (ΙΣΑ) για τη χορήγηση αντιβιοτικών χωρίς ιατρική συνταγή. Όπως...